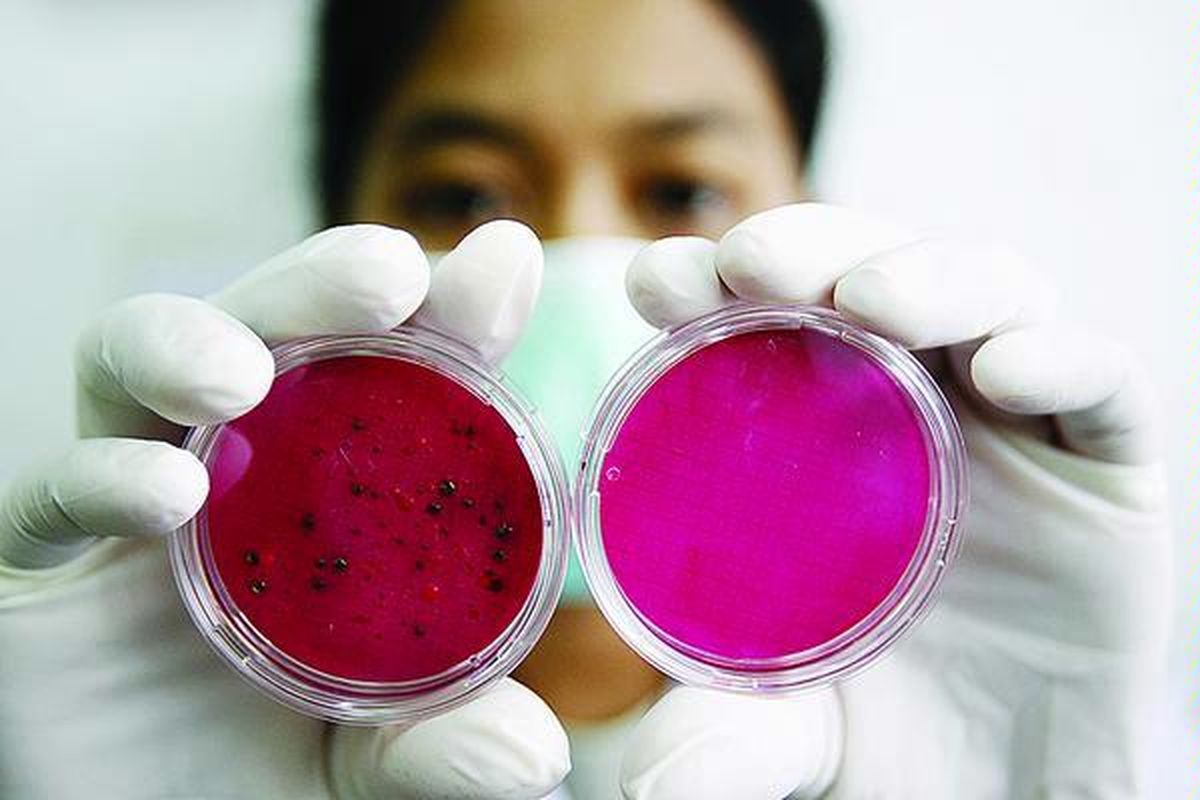
Petugas laboratorium menunjukkan coli form yang berisi koloni bakteri hasil penyaringan dengan proses laminar flow (kiri) dan coli form yang sudah bersih dari bakteri (kanan) dari sampel air baku di ruang laboratorium instalasi pengolahan air Palyja, Jakarta, Jumat (5/3). Proses penyaringan mikrobiologi dilakukan untuk mengetahui kadar bakteri dalam air baku.

Cepat atau Lambat, Bakteri Makin Kebal
JAKARTA, KOMPAS.com - Munculnya bakteri super yang resisten terhadap berbagai antibioitik paling ampuh sekalipun bukanlah hal baru dalam dunia kedokteran. Cepat atau lambat, bakteri memang akan menjadi resisten terhadap antibiotik (multiresisten) yang ada saat ini.
"Tidak ada antibiotik yang sensitif (mampu bertahan lama) dalam membunuh bakteri. Para ahli mikrobiologi menganggap, antibiotik bukan merupakan cara tepat untuk menangani penyakit. Karena apabila peneliti menemukkan antibiotik untuk membunuh bakteri, tahun-tahun berikutnya bakteri akan menjadi resisten terhadap antibiotik yang ada," kata Prof. Sam Soemarto dari PAMKI (Perhimpunan Ahli Mikrobiologi Klinik Indonesia), Kamis (12/08/10).
Menurut Prof. Sam, pada dasarnya bakteri menjadi resisten karena banyak cara. "Pertama, memisahkan dirinya secara genetik. Kemudian dia bisa tumbuh menjadi bakteri baru yang kebal karena adanya proses mutasi dan transfer gen antibiotik ke bakteri lain," jelas Prof. Sam.
Mutasi sendiri ialah terjadinya modifikasi protein, yaitu penurunan afinitas ikatan protein bakteri dengan antibiotik. Protein akan tahan terhadap kehilangan efisiensi karena mutasi tersebut. Nantinya, mutasi genetis yang berbeda akan menghasilkan tipe resistensi yang berbeda juga.
"Beberapa mutasi mengakibatkan bakteri dapat menghasilkan zat kimia (enzim) yang cukup untuk menonaktifkan antibiotika. Hal yang sama terjadi pada bakteri super yang menghasilkan enzim NDM-1," kata Prof Sam.
Selain itu, menurut Prof, Sam Soemarto, resistensi juga terjadi karena bakteri mentransfer gen antibiotik ke bakteri lain. Bakteri bisa mendapatkan gen-gen resisten terhadap antibiotika dari bakteri lain dengan beberapa cara. Dengan melakukan proses perkawinan sederhana yang disebut “konjugasi,” bakteri dapat mentransfer materi genetik, termasuk kode-kode genetik yang resisten terhadap antibiotika (ditemukan dalam plasmids and transposons) dari satu bakteri ke bakteri yang lainnya.
Bakteri yang mendapatkan gen-gen resisten, baik melalui mutasi spontan atau melalui pertukaran genetis dengan bakteri lainnya, memiliki kemampuan untuk melawan satu atau lebih jenis antibiotika. Karena bakteri dapat mengumpulkan beberapa sifat resistensi seiring dengan berjalannya waktu, mereka dapat menjadi resisten terhadap beberapa jenis antibiotika yang berbeda.
Penggunaan tidak tepat "Resisten dari bakteri itu sendiri bisa dipercepat oleh pola pemakaian antibiotik(resep) yang dipakai dakter tidak tepat," kata Prof Sam.
Menurut Prof. Sam, kebanyakan resep untuk penyakit tertentu seharusnya tidak perlu menggunakan antibiotik. Misalkan resep untuk flu, yang diketahui jelas bahawa penyakit flu berasal dari virus, sehingga tidak terpengaruh oleh pemberian antibiotik.
Selain itu Prof. Sam menjelaskan bakteri yang mengalami resistensi terhadap antibiotika juga disebabkan karena adanya penyalahgunaan dan penggunaan antibiotik yang dapat dibeli tanpa resep dokter. "Pasien suka minum antibiotik tertentu padahal belum tentu obat itu mengobati penyakitnya, " kata Prof. Sam.
Padahal, penggunaan antibiotik yang sembarangan dapat menghasilkan jenis bakteri baru yang dapat bertahan terhadap pengobatan yang diberikan atau yang disebut dengan resistensi bakteri. Jenis bakteri baru ini memerlukan dosis yang lebih tinggi atau antibiotika yang lebih kuat untuk dapat dimusnahkan.
Di sisi lain, lanjut Prof. Sam, kebiasaan pasien tidak menghabiskan antibiotik yang diberikan dokter juga berpengaruh untuk meningkatkan resistensi dari bakteri tersebut.
KOMPAS.com berkomitmen memberikan fakta jernih, tepercaya, dan berimbang. Dukung keberlanjutan jurnalisme jernih dan nikmati kenyamanan baca tanpa iklan melalui Membership. Gabung KOMPAS.com Plus sekarang














